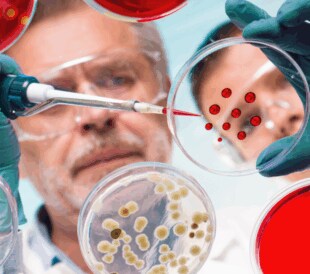
AAV-SEC Analysis: Top 3 Takeaways From the Latest Article

Introduced nearly 80 years ago, collision-based ion-activati...
Read More Collision-Based Ion-activation and Dissociation
Your educational resource for biopharma, pharma, environmental, food and agriculture, industrial, and clinical labs
Your educational resource for biopharma, pharma, environmental, food and agriculture, industrial, and clinical labs

Introduced nearly 80 years ago, collision-based ion-activati...
Read More Collision-Based Ion-activation and Dissociation
What is the best column for separating AAV size variants? Th...
Read More AAV-SEC Analysis: Top 3 Takeaways From the Latest Article
The field of oligonucleotide therapeutics is expanding due t...
Read More Consider Semi-preparative Columns to Improve Your Oligonucleotide Analysis
What are oligonucleotide therapies? Oligonucleotide therapie...
Read More Oligonucleotide Therapeutics: A Beginner’s Guide
If you’re new to the world of biopharma analysis, hereÃ...
Read More Oligonucleotide Therapeutics: A Biopharmaceutical Basics Overview
The authors of a paper in Journal of Chromatography A found ...
Read More gRNA Analysis Where s the Best Place to Start?